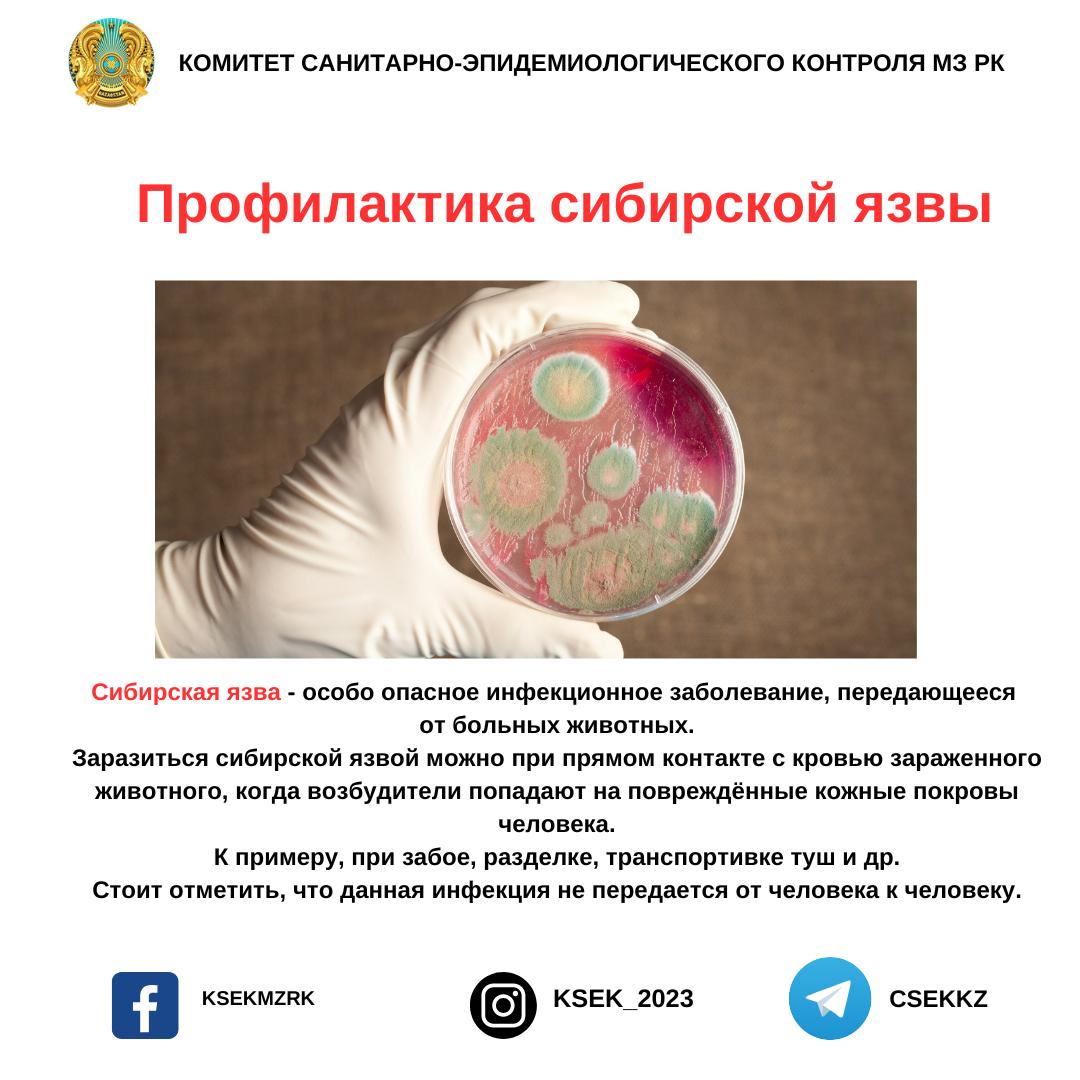

Колония сибирской язвы
Колония сибирской язвы 111 фотографий
Джон гейси замаскированный дьявол
Факты про этикет
Конвектор площадь обогрева
Дикси тутаев
Слова татара
Метро исход крест
Вебка стрим 18
Секрет небес реквием гайд фавориты
Новотроицк оренбургская область видео
Волгоградские помидоры описание выращивание
Рыба окунь речной описание
Сколько ккал в обеде
Покажи фотографию денег
Мужской триммер филипс
Салават фатхетдинов сагынырсын
Light comparative and superlative
Иштхон пагода
Уведомление вестника государственной регистрации
Кто должен благословлять
Казашки на пляже